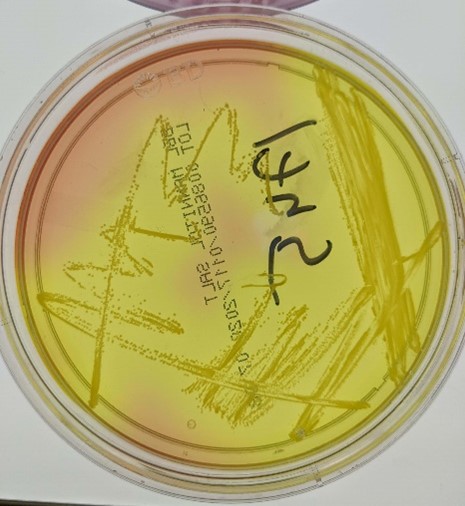

From MARC Student to MacArthur Fellow

“I study the dance between a bacterium and its host. If we can decode the secrets of that dance—how the pathogen causes disease, and how the host fights back—we might be able to take advantage of vulnerabilities to improve our ability to combat infections,” says Víctor J. Torres, Ph.D., the C. V. Starr Professor of Microbiology at the New York University (NYU) Grossman School of Medicine in New York City.
Discovering and Pursuing a Passion for Science
Growing up, Dr. Torres never would have imagined his highly successful scientific career, especially since he didn’t have a strong interest in science. He entered the University of Puerto Rico, Mayagüez, in 1995, planning to participate in the Reserve Officers’ Training Corps and join the Air Force after graduation. He struggled during his first year of college and had to repeat several courses. In one of those courses, he met a fellow student who was planning to pursue a career in science—his now wife, Carmen A. Perez, M.D., Ph.D., who’s a radiation oncologist at NYU Langone. She shared with Dr. Torres some of the opportunities in science available to him, including the NIGMS-funded Maximizing Access to Research Careers (MARC) program at their university.
Dr. Torres’ fascination with biology—especially microbiology—grew, and he applied for the MARC program near the start of his third year of college. He wasn’t initially accepted, but when a spot in the program opened, the directors offered it to him, recognizing his passion for science. “Without the MARC program, I wouldn’t be where I am today,” he says.
The MARC program not only enabled Dr. Torres to gain experience with research for the first time but also provided him with financial support so he could stop working outside of the lab. He formed close relationships with his MARC mentors and still keeps in touch with them today.
After graduating with his bachelor’s degree, Dr. Torres entered a microbiology and immunology Ph.D. program at Vanderbilt University School of Medicine in Nashville, Tennessee. He worked in the lab of Timothy Cover, M.D., investigating the toxin made by Heliobacter pylori, a bacterium that has been linked to ulcers and stomach cancer. He also applied for and received his first grant, an NIGMS Ruth L. Kirschstein National Research Service Award predoctoral fellowship. “Being awarded that grant reassured me that I could compete for independent funding, a critical aspect of a career in academia,” Dr. Torres says.
He went on to a postdoctoral position in the lab of Eric Skaar, Ph.D., at Vanderbilt. He applied for and received his second grant, a fellowship from the National Institute of Allergy and Infectious Diseases (NIAID). As a postdoc, Dr. Torres studied the bacterium Staphylococcus aureus and how this pathogen causes diseases. Dr. Skaar had started his lab only 6 months before Dr. Torres joined, so Dr. Torres not only learned science but also how to assemble a lab and how to mentor by watching Dr. Skaar. “That training was extremely critical for me when I set up my lab at NYU in 2008,” Dr. Torres says.
Seeking the Achilles’ Heel of S. aureus
Dr. Torres’ lab primarily studies S. aureus, including methicillin-resistant S. aureus (MRSA), which doesn’t respond to some antibiotics. Some people carry S. aureus in their noses and on their skin, and it typically doesn’t do any harm. However, if the bacterium enters the bloodstream or other parts of the body where it isn’t usually found, it can cause life-threatening infections.
Dr. Torres hopes that better understanding how S. aureus and its toxins interact with human cells will lead to new ways to prevent and treat infections. His lab discovered that S. aureus toxins target certain receptors on immune cells and showed that blocking the interaction between toxin and receptor could help treat infections. The realization that S. aureus toxins harm specific cells, rather than attacking the host indiscriminately, could also support the development of a vaccine for S. aureus infections that block the toxins that attack immune cells.
Dr. Torres is collaborating with the pharmaceutical industry to develop several therapies based on his discoveries. “I think this is a great example of how you can start with basic science and then begin moving those discoveries into hopefully lifesaving approaches,” he says.
Using Success to Support Students

Throughout his career, Dr. Torres has received many awards. One of the most recent and prestigious is a 2021 MacArthur Fellowship (unofficially referred to as a “Genius Grant”), a 5-year grant given to peer-nominated individuals who show exceptional creativity in their work. Dr. Torres feels honored that the MacArthur Fellowship enables him to represent Puerto Rico, microbiology, and “less-than-perfect students” in a highly visible way. He adds, “These awards are somewhat unfair because they’re given to me when I’m just the vessel. My name is on the lab door, but it’s the whole team that does the work.”
One of Dr. Torres’ key focuses, in addition to helping solve the problem of S. aureus infections, is training young scientists. “Mentoring is my biggest responsibility, and the one that I love the most,” he says. Dr. Torres feels it’s especially important to support underrepresented minority students and those who are passionate about science but don’t have the most academic accolades. He wants to give these students opportunities that will help launch scientific careers, just like the MARC program directors at the University of Puerto Rico, Mayagüez, did for him.
Dr. Torres was supported by NIGMS grants T34GM008419 and F31GM070061 as a student. His current research is supported by grants from NIAID.